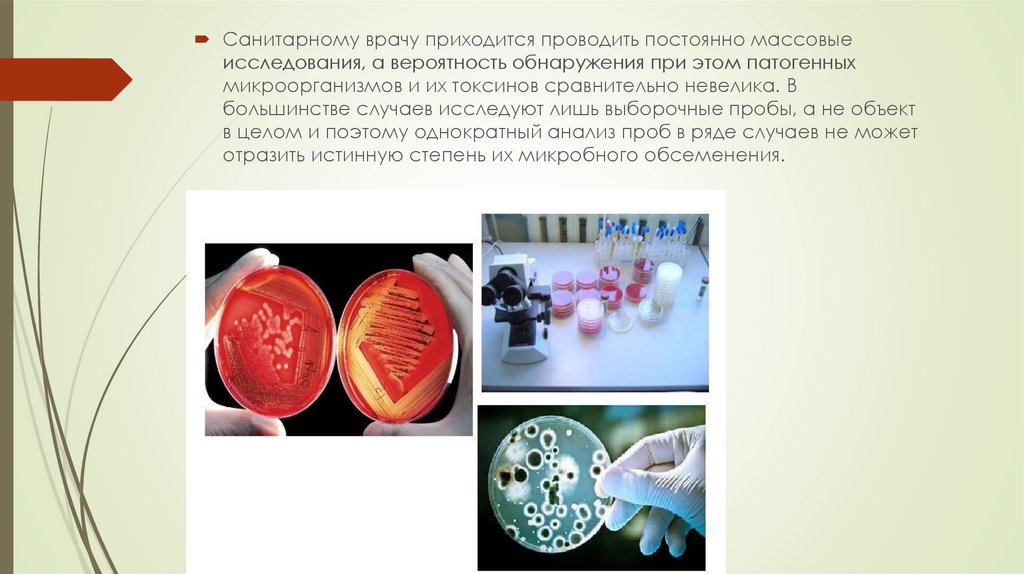

Похожие презентации:
Значение санитарной микробиологии и ее задачи
1. Значение санитарной микробиологии и ее задачи
2.
Санитарная микробиология предусматриваетуспешное решение задач, связанных с повышением
качества и биологической ценности продуктов
питания, необходима система мероприятий,
улучшающая санитарно-гигиеническое состояние
производства, а также условия окружающей среды.
3. Задачи санитарной микробиологии в мясной и молочной промышленности могут быть сформулированы следующим образом:
- разработкаи оценка методов обнаружения
патогенных микроорганизмов в мясных и молочных
продуктах;
- разработка норм предельно допустимого
бактериального обсеменения мясных и молочных
продуктов;
- санитарно-микробиологический контроль качества
сырья, полуфабрикатов, готовой продукции, а также
их производства на всех этапах технологического
процесса.
4.
Знание основных положенийсанитарной микробиологии
необходимо каждому
санитарному врачу для
правильной ориентации во всех
санитарно-гигиенических
вопросах, в частности при
санитарной оценке почвы, воды,
воздуха, пищевых продуктов;
обследовании случаев пищевых
отравлений, их профилактике;
организации и гигиенической
оценке очистки и
обезвреживания различных
объектов; контроле личной
гигиены работников пищевых
предприятий и др.
5.
Санитарный врач должен уметь правильно организоватьсанитарно-микробиологические исследования объекта,
хорошо представлять возможность своевременного проведения
мероприятий, исключающих отрицательное влияние его на
организм человека или животных.
связи с этим санитарный врач должен знать биологические
особенности микроорганизмов, обусловливающих порчу
пищевых продуктов, методы микробиологических и
вирусологических исследований, используемых для оценки
объектов внешней среды (почвы, воды, воздуха), с учетом
достижений физики, химии, генетики, биологии и других
научных дисциплин, а также методы оценки путей и степени
инфицирования животными и человеком окружающей среды
патогенными бактериями и вирусами; нормальный
взаимообмен микрофлорой между животными, людьми и
окружающей средой; производственные и бытовые процессы,
обусловливающие нарушение естественного самоочищения и
обеззараживания внешней среды.
6.
Пищевые продукты почти всегда в значительнойстепени обсеменены различными бактериями.
Поэтому при исследовании их приходится учитывать
нормальное течение микробиологических
процессов и те возможные изменения, которые
вызывает в продукте необычная для него
микрофлора, попадающая при нарушении условий
выработки и хранения продукта.
7.
Санитарному врачу приходится проводить постоянно массовыеисследования, а вероятность обнаружения при этом патогенных
микроорганизмов и их токсинов сравнительно невелика. В
большинстве случаев исследуют лишь выборочные пробы, а не объект
в целом и поэтому однократный анализ проб в ряде случаев не может
отразить истинную степень их микробного обсеменения.
8.
Следовательно, задачейэтих исследований
является выяснение лишь
потенциальной
опасности того или иного
объекта для людей и
животных, то есть
присутствия в нем
патогенных
микроорганизмов, а не
прямое их обнаружение.
В этом одно из отличий
санитарномикробиологи
ческого анализа от
диагностических
исследований.
9.
Санитарно-микробиологический анализ продукта должен выявитьвозникшие в нем изменения и дать рекомендации для объективного
заключения о пригодности исследуемого продукта для употребления
или его опасности для человека. При этом санитарный врач несет
большую ответственность не только за состояние здоровья людей, но и
за экономический ущерб, который может быть результатом
необоснованного заключения о браковке продукта. Исследуемые
продукты (объекты) обычно оценивают по результатам ряда санитарномикробиологических тестов с учетом органолептических,
биохимических и других показателей. Поэтому государственные
общесоюзные стандарты (ГОСТ) и технические условия (ТУ) включают
микробиологические нормы лишь как один из элементов,
характеризующих исследуемые объекты.

Биология
Биология








